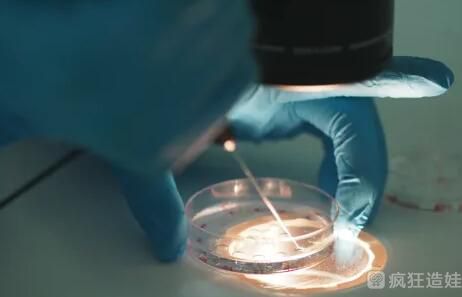
吉林三代试管婴儿医院排名怎么样？吉林三代试管婴儿去哪做？

-

2022年国家免费做试管婴儿是真的吗?免费试管去哪做?
2022年国家免费做试管婴儿是真的吗?免费试管去哪做?家里经济不好,结婚4年,房贷每个月几万。现在已经确诊不孕,医生建议做试管。本来我就没有一颗强大的心,承受不了试..
2023-07-10 11:56 -

南京三代供卵试管医院排名?南京三代试管去哪做?
南京三代供卵试管医院排名?南京三代试管去哪做?我和老公去做孕前检查的时候,发现身体有问题,怀不上。医生建议我们用试管。想去成功率高的医院。目前,我们住在江苏省南..
2023-07-12 11:44 -

济南不孕不育医院排名?济南试管去哪做?
济南不孕不育医院排名?济南试管去哪做?据统计,到2022年初,山东省已有32家医院能够开展辅助生殖技术,包括济南市8家医院、山东大学附属生殖医院、山东大学齐鲁医院、山..
2023-07-15 11:14 -

海南供卵试管不排队的医院有哪些?海南供卵试管去哪做?
海南供卵试管不排队的医院有哪些?海南供卵试管去哪做?在外地打拼多年,认识了现在的老公,婚后一直没怀上孩子,后来去医院检查卵巢早衰。医生说可能是过度劳累造成的。的..
2023-10-19 17:38 -

海南供卵第三代试管婴儿不排队的医院有哪些?海南供卵第三代试管婴儿去哪做?
海南供卵第三代试管婴儿不排队的医院有哪些?海南供卵第三代试管婴儿去哪做?在外地打拼多年,认识了现在的老公,婚后一直没怀上孩子,后来去医院检查卵巢早衰。医生说可能..
2024-04-27 10:25 -

涿州市第三代试管婴儿去哪做?涿州市第三代试管婴儿大概要多少钱?
现在技术慢慢的扩散到了全国,就连很多地级县市也已经出现了能做第三代试管婴儿的医院,虽然从大部分时候来看,的确那些更好的医院试管医院成功率会更高一些,但如果从距离..
2024-09-19 10:35 -

2023年国家免费做第三代试管婴儿是真的吗?免费试管去哪做?
2023年国家免费做是真的吗?免费试管去哪做?家里经济不好,结婚4年,房贷每个月几万。现在已经确诊不孕,医生建议做第二代试管。本来我就没有一颗强大的心,承受不了试管..
2024-09-26 10:40 -

山东第三代试管婴儿应该去哪做?附山东第三代试管婴儿费用明细
在山东做之前,大部分人总会有这样或那样的一些疑问,比如山东哪里做第三代试管婴儿,山东哪里做高。面对这些问题,总会花很多时间去寻找答案。那么山东试管婴儿应该去哪做..
2024-09-27 09:07 -

广州天河上户口亲子鉴定去哪做
广州天河上户口亲子鉴定去哪做?上户口亲子鉴定需要到正规司法鉴定所办理,这样出具的司法亲子鉴定报告才具有法律效力,才能用来上户口。DNA亲子鉴定中心司法鉴定所是正规..
2024-10-07 09:25 -

济南不孕不育医院排名?济南第三代试管婴儿去哪做?
济南医院排名?济南试管婴儿去哪做?据统计,到2022年初,山东省已有32家医院能够开展辅助生殖技术,包括济南市8家医院、山东大学附属生殖医院、山东大学齐鲁医院、山东中..
2024-10-25 10:04 -
吉林三代试管婴儿医院排名怎么样?吉林三代试管婴儿去哪做?
吉林三代试管婴儿医院排名怎么样?吉林三代试管婴儿去哪做?目前国内批准实施的技术有三代,第三代是最难的一代,但不代表第三代就是最好的,只是适用的情况不同。吉林省共..
2024-12-27 09:43 -

十堰做试管婴儿哪家成功率高?第三代试管婴儿去哪做?
现在作为一种非常优异的辅助生殖技术,已经被很多的患者所广泛的接受了。由于现代人出现普遍的晚婚晚育和污染等问题,越来愈多的人开始出现不孕不育症状,而且一般问题都很..
2025-10-22 10:31 -

河南三代试管婴儿医院排名怎么样?河南三代试管婴儿去哪做?
河南三代试管婴儿医院排名怎么样?河南三代试管婴儿去哪做?附院和成功率。目前,第三代试管婴儿医院代表了中国允许的试管婴儿技术的最高水平。作为全国人口大省和最多的省..
2025-10-23 10:57 -

南京三代供卵试管婴儿医院排名?南京三代试管婴儿去哪做?
南京三代供卵试管婴儿医院排名?南京三代试管婴儿去哪做?我和老公去做孕前检查的时候,发现身体有问题,怀不上。医生建议我们用试管婴儿。想去成功率高的医院。目前,我们..
2025-11-11 10:32
微信分享
扫描二维码分享到微信或朋友圈